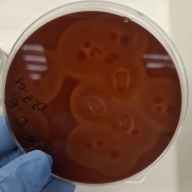
отит у собак 10022026

Альбомы
-

Золотая Нива 26052026
3 фотографии
-

клещи_16052026
2 фотографии
-

возложение цветов_08052026
2 фотографии
-
совещание_07052026
11 фотографий
-

сад памяти_06052026
7 фотографий
-

иксодовые клещи
2 фотографии
-

Саркоцистоз животных_28042026
2 фотографии
-

секвенирование_24.04.2026
6 фотографий
-

обучение бактериологов паразитологов
2 фотографии
-
обучение инфекциологов
2 фотографии
-
обучение паразитологов 15042026
2 фотографии
-

угроза пальмам_14042026
4 фотографии
-

проверка продуктов
2 фотографии
-
повышение квалификации_07.04.2026
4 фотографии
-

дроны Геоскан
3 фотографии
-

секвенирование_31.03.2026
4 фотографии
-
Курсы МеркурийХС
3 фотографии
-

нодулярный дерматит_20032026
2 фотографии
-

собрание пчеловодов_17032026
2 фотографии
-

совещание в Крыловской_13032026
6 фотографий
-

совещание в Приморско-Ахтарске_13032026
4 фотографии
-

обучение сотрудника_13032026
2 фотографии
-

инфекция_10032026
5 фотографий
-
лекция 8 марта_06032026
15 фотографий
-

Народный фермер_05032026
1 фотография
-
Учеба ФГИС ВЕСТА_03032026
4 фотографии
-

подготовка к посевной 25022026
1 фотография
-

Возложение цветов 21022026
3 фотографии
-

Лекция_19022023
6 фотографий
-

микробиология-13022026
3 фотографии
-
отит у собак 10022026
2 фотографии
-

Репортаж_06022026
4 фотографии
-
обучение по физико-химическим методам исследования пищевых продуктов 20012026
4 фотографии
-

Новогодняя открытка 2025
1 фотография
-
125_летие_лаборатории
5 фотографий
-

филометроидоз_12122025
4 фотографии
-

микрофлора у попугая-01122025
6 фотографий
-

КПК_паразитология_28.11.2025
2 фотографии
-
студенты в гостях_26112025
6 фотографий
-
ЮГАГРО_2025
6 фотографий
-

Повышение квалификации 07112025
3 фотографии
-
День народного единства_31102025
6 фотографий
-
совещание_30102025
4 фотографии
-

озимый рапс_28102025
1 фотография
-

обучение бактериология 20102025
4 фотографии
-

обучение_20102025
3 фотографии
-
экскурсия студентов 16102025
5 фотографий
-

отит у собаки_14102025
5 фотографий
-
обучение_10102025
5 фотографий
-

смешанная кишечная инфекция 03102025
5 фотографий
-

таблицы вакцин_29092025
14 фотографий
-

surikat_19092025
7 фотографий
-
Субботник_12092025
6 фотографий
-

бруцеллез_12092025
1 фотография
-

вторичная инфекция_09092025
4 фотографии
-

сепсис_05092025
3 фотографии
-

электрофорез_02092025
3 фотографии
-

День ветеринарного работника 31082025
4 фотографии
-
Заврешение курсов повышения квалификации в Учебном Центре ФГБУ «ВНИИЗЖ»_25.08.2025
3 фотографии
-
итоги в области семеноводства-16.07.2025
3 фотографии
-

Обучение Нематоды
3 фотографии
-

День поля 09.06.2025
2 фотографии
-
Обучение РСХН 05.06.2025
4 фотографии
-

День карантинной службы
3 фотографии
-
Совещание-30052025
4 фотографии
-

Нива Кубани 2025
5 фотографий
-

Сад памяти_07052025
5 фотографий
-

Возложение цветов_07052025
5 фотографий
-
Концерт ко Дню Победы-06052025
7 фотографий
-

29042025 ППЖ
3 фотографии
-

25042025 Народный фермер Кубани
5 фотографий
-
25042025 выставка INTER FOOD
7 фотографий
-
субботник-17042025
7 фотографий
-

Поздравление директора с 8 Марта_07032025
4 фотографии
-
Лекция Первые Женщины России
3 фотографии
-
Лекция ко дню Защитника Отечества_20.02.2025
3 фотографии
-

научная конференция_11022025
4 фотографии
-

Ликвидация последствий Анапа 2024
8 фотографий
-
Ёлка желаний 2024
5 фотографий
-

чемпионат по плаванию
5 фотографий
-
Собрание итоги 2024
13 фотографий
-

свеча
1 фотография
-
Кураторский час
3 фотографии
-
Встреча с Агрокомплексом-14112024
3 фотографии
-

АЗИЯ ЭКСПО 23.10.2024
4 фотографии
-

Cовещание с представителями хозяйствующих субъектов Краснодарского края
4 фотографии
-
Собрание 11.10.2024
2 фотографии
-

9 мая
1 фотография
-

22 августа - День Государственного флага России
7 фотографий
-
Награждение ко Дню России
18 фотографий
-

АРХИВНЫЕ ФОТОГРАФИИ
20 фотографий
-

Минувших лет живая память
1 фотография
-

Русский Г.А._Василенко В.И.
2 фотографии
-

Стена Памяти
7 фотографий
-

Поход в музей
10 фотографий
-
Бессмертный полк_Ветераны сотрудников
5 фотографий
-
Чистый четверг
10 фотографий
-

Коллегия Россельхознадзора
7 фотографий
-
На пути к победе
9 фотографий
-
Экскурсия студентов КУбГАУ
6 фотографий
-

Орган инспекции ФГБУ КМВЛ
10 фотографий
-
Совещание 13.10
32 фотографии
-
"Зеленая Россия"
25 фотографий
-

День Поля гибриды кукурузы
6 фотографий
-
"Золотая Нива"
12 фотографий
-

СемСтандарт
3 фотографии
-

21 апреля 2022
27 фотографий
-
Совещание 07.04
7 фотографий
-

АРХИВНЫЕ ФОТОГРАФИИ
14 фотографий
-

Обучение
4 фотографии
-

Итоговое совещание 23.12.2021
9 фотографий
-
Экскурсия на семенной завод РАТ
12 фотографий
-
ООО "Русский гриб"
9 фотографий
-
Павловский район 21.10.2021
14 фотографий
-
Поездка в Ейск 19.10
11 фотографий
-

День работника сельского хозяйства и перерабатывающей промышленности
15 фотографий
-

Открытие региональной лаборатории по Республике Адыгея
9 фотографий
-
Зеленая Россия
12 фотографий
-
мэб
3 фотографии
-

семеноводство электрофорез
2 фотографии
-

уборка
8 фотографий
-
сертификация семян
1 фотография
-

фото лаборатория
31 фотография
-

лицензии учебный
3 фотографии
-
хти
5 фотографий
-

заявление о политике в области качества
1 фотография
-
олэкр
8 фотографий
-

семеноводство
3 фотографии
-
карантин растений
4 фотографии
-

агрохимия
3 фотографии
-

бактериологи
4 фотографии
-

Учебный центр
0 фотографий
-

всэ
2 фотографии
-
вирусология
3 фотографии
-
лабораторные животные
2 фотографии
-

прием проб диагностика
1 фотография
-

патоморфология
2 фотографии
-

пит среды
2 фотографии
-
радиология
2 фотографии
-

серология
2 фотографии
-

ОПРРП
1 фотография
-
Альбом отдел по качеству
1 фотография
-

Тестовый альбом для отдела (530x350)
3 фотографии
-

Альбомы отделов - испытательный центр (720x480)
2 фотографии
-

Альбомы отделов - фитосанитарное направление (720x480)
3 фотографии
-

Альбом отделов - ветеринарное направление (720x480)
3 фотографии
-

Тестовый альбом
4 фотографии
-

Видео на главной
2 фотографии
-

Главный слайдер
6 фотографий
-

Важная информация
8 фотографий






































































































